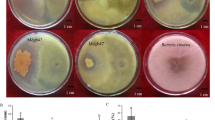
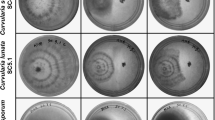

Abstract
Bacillus subtilis is a potent biocontrol agent producing a wide array of antifungal lipopeptides for the inhibition of fungal growth. B. subtilis B1 isolated from market-available compost provided an efficient control of rubberwood sapstain fungus, Lasiodiplodia theobromae. The current study is aimed to identify and characterize the lipopeptides responsible for the biocontrol of rubberwood sapstain fungus by Bacillus subtilis B1. The bacterial whole-cell surface extract from the dual culture of B. subtilis B1 and sapstain fungus (L. theobromae) was analysed using MALDI-TOF-MS. The protonated as well as sodium, potassium adducts of homologues of iturin C, surfactin, bacillomycin D and fengycin A and B were identified and expression of the lipopeptide biosynthetic genes could be confirmed through RT-PCR. This is the first report of mycobacillin and trimethylsilyl derivative of bacilysin during antagonism through MALDI-TOF-MS. MALDI-TOF-MS with RT-PCR offered easy platforms to characterize the antifungal lipopeptides. The identification of antifungal lipopeptides can lead to the formulation of prospective biocontrol by-products which have wide-scale utility.
Similar content being viewed by others
Avoid common mistakes on your manuscript.
Introduction
In India, rubberwood (Hevea brasiliensis) has emerged as a main source of wood material with immense applications across all sectors of wood industry. Globally, India is the fourth largest natural rubber-producing country and Kerala State accounts for 78 % of the area and 90 % of total rubber produced in the country [13]. Even though an eco-friendly wood material, the non-durability of rubberwood makes it highly susceptible to fungal infection in the warm and humid tropical climate. Sapstain fungi, which cause high economic loss to the timber industry by reducing the aesthetic value of the wood, is also a serious issue in rubberwood industry [8]. Lasiodiplodia theobromae, the dominant bluish black sapstain fungus, badly attacks the rubberwood within 1 day of felling and infects the full log in a span of 1 week [12]. Although chemical fungicides are commonly used for rubberwood preservation, environment-friendly biocontrol measures are preferred to reduce the health hazards and environmental pollution. Different microbes like Trichoderma, Pseudomonas, and yeast among others were used as biocontrol agents against L. theobromae on fruit crops like guava, banana, cashew, annona, etc. [1, 14, 15, 43], but so far no studies had been undertaken on the biological control of L. theobromae on rubberwood.
One of the first flourished biocontrol agents used against insects and pathogens was the members of the genus Bacillus [36]. B. subtilis collectively with other Bacillus species represent about half of the industrially available biopesticides in the world market [11]. B. subtilis has been regarded as a paradigm of Gram-positive endospore-forming bacteria [29]. Various strains of B. subtilis are widely exploited as biocontrol agents because of their safety, extensive distribution in varied habitats and their significant ability to endure unfavourable conditions by the development of endospores. The biocontrol property of Bacillus has been explained by different mechanisms of action including competition for space and nutrients, production of cell wall-degrading enzymes and antibiosis [2]. The potential of B. subtilis is based on its ability to produce a broad array of less toxic lipopeptides with powerful antifungal properties, high biodegradability and eco-friendly features as compared to chemical pesticides [6, 28].
Among these, non-ribosomally synthesized lipopeptides like iturin, surfactin and fengycin families are most commonly known for their antifungal and biosurfactant activities [18, 21, 31, 34]. Iturin A and C, bacillomycin D, F, L and LC and mycosubtilin were explained as the seven main members of the iturin family. The fengycin family of lipopeptides includes fengycin A and B, which are also known as plipastatins. Biological control of rubberwood sapstain fungus, L. theobromae, had been attempted previously using Trichoderma sp. and Streptomyces sp., but the results were not promising [41, 48]. The successful and significant inhibition of rubberwood sapstain fungus was observed in the study using B. subtilis B1 isolated from market-available compost [42]. Understanding the mechanisms of biological control helps to manipulate the environment to create congenital conditions for better biocontrol [45]. Several studies had been carried out for the identification of antifungal lipopeptides in various strains of B. subtilis [4, 21, 34]. Till date, there is no information on the family of antifungal lipopeptides produced by B. subtilis during antagonism of sapstain fungus on rubberwood. Matrix-assisted laser desorption/ionization time of flight-mass spectrometry (MALDI-TOF-MS) has been regarded as a very fast and reliable tool for the identification of lipopeptides when compared to the conventional methods like culturing and purifying the lipopeptides. The effectiveness of MALDI-TOF-MS for the identification of Bacillus cyclic peptides and other lipopeptides has been previously reported [4, 21].
In this context, the objective of the present study was to identify and characterize the antifungal lipopeptides produced by B. subtilis B1 during the inhibition of rubberwood sapstain fungus (L. theobromae) using MALDI-TOF-MS as well as through reverse transcriptase PCR (RT-PCR).
Materials and Methods
Bacillus subtilis B1 Isolation, Identification and Antagonism
Protocols for the isolation of the bacterial biocontrol agent, morphological/biochemical/molecular identification of Bacillus subtilis B1 as well as its antagonistic potential have been standardized [42].
Structural Characterization of the Sapstain Fungus During Antagonism
The dual culture of rubberwood sapstain fungus (L. theobromae) as well as the biocontrol agent (B. subtilis B1) was performed according to Johnson and Curl [19]. B. subtilis B1 was streaked on one side of the potato dextrose agar (PDA) plate and a 6-mm-width disc of actively growing L. theobromae was simultaneously inoculated on the opposite side of the plate and incubated at 28 °C. L. theobromae culture grown in PDA was used as a control. The mycelial portion from the inhibition zone was viewed under the light microscope as well as subjected to scanning electron microscopic (SEM) study to understand the structural changes in the fungal mycelia during antagonism, induced by the biocontrol agent, B. subtilis B1 [5].
MALDI-TOF-MS Analysis of Antifungal Lipopeptides
The antifungal lipopeptide analysis was done from the bacterial whole-cell surface extract obtained during the dual culturing of B. subtilis B1 and L. theobromae. Preparation of bacterial surface extracts was carried out according to the methodology of Vater et al. [47]. Instead of antibiotic production medium Landy agar, the growth medium, potato dextrose agar, was used in this study. B. subtilis B1 was streaked on one side of the plate and L. theobromae was placed on the opposite side simultaneously and incubated at 28 °C. On the second day, one to two loops of bacterial cells from the interface of the bacterial–fungal dual culture was suspended in 500 µL of acetonitrile (70 %) with trifluoroacetic acid (0.1 %) for 2 min. This was gently vortexed and the homogenized suspension was pelleted by centrifuging at 5000 rpm for 10 min. Dihydroxy benzoic acid (DHB) was used as the matrix solution in MALDI-TOF-MS analysis. The cell-free supernatant was stored in fresh microcentrifuge tubes at 4 °C for MALDI-TOF-MS analysis. The MALDI-TOF-MS analysis was carried out at Indian Institute of Sciences, Bangalore, India. The mass range used for the analysis was from 200 to 2000 Da. The surface extract of B. subtilis B1 grown on potato dextrose agar was used as a control in this study.
Characterization of Antifungal Lipopeptide Synthetic Genes Using Reverse Transcriptase PCR (RT-PCR)
For confirming the antifungal lipopeptide gene expressions during antagonism, the total RNA was isolated from the B. subtilis B1 using RNeasy Mini Kit (Qiagen, USA) according to the manufacturer’s instructions. The RNA was isolated from the B. subtilis B1, dual cultured with L. theobromae having a visible inhibition zone. The concentration and purity of the isolated RNA were determined by measuring the absorbance at 260/280 nm (NanoDrop 1000, Thermo Scientific, USA). The total mRNA was used as the template for the cDNA synthesis using first-strand cDNA synthesis kit (Fermentas, Lifesciences). The synthesized cDNA was used as the template for the RT-PCR. To characterize the genes, the cDNA was amplified using the specific primers for each lipopeptide biosynthetic gene (Table S1). cDNA-PCR amplification was carried out as per standard protocols with a preliminary denaturation step at 94 °C for 5 min followed by 35 cycles of denaturation (94 °C for 1 min), primer annealing (different annealing temperatures). After 35 cycles of PCR amplification, the PCR products were resolved on 1.5 % agarose gel and the eluted products were subjected to Sanger’s dideoxy sequencing. The similarity searches for the sequences were carried out using the BLAST (N) option in the NCBI genbank (www.ncbi.nlm.nih.gov).
Scale-Up Production of Bacillus subtilis B1 in Bioreactor
The batch fermentations were performed in a 3L LS2 bioreactor (Scigenics, India), equipped with an agitator shaft with three impellers and connected to a digital control unit. Temperature and pH were measured using the probes, and the pH was maintained by automatic feeding of 1 N NaOH and 1 N HCl. Compressed air was supplied through the sterile filter. The agitation and aeration could be manually controlled in parallel to the dissolved oxygen. The dissolved oxygen level and pH were controlled and measured. Foaming was eliminated using the antifoam agent silicone oil (Himedia, India).
Based on the preliminary shake flask studies on the standardization of medium and physical factors for the massive growth of B. subtilis B1, molasses peptone broth (MPB) with pH 7 at 30 °C was used in the bioreactor for scale-up production. The batch process was started with an initial volume of sterile 2.5 L MPB (Molasses 10 %, peptone 0.25 %) at pH 7 and inoculated with 25-ml shake flask pre-inoculated B. subtilis B1 culture. In the bioreactor, the optimum aeration and agitation were standardized using a range from 0.5 to 3 lpm (liquid per minute) and 0 to 350 rpm (rotation per minute), respectively. The dissolved oxygen set at the beginning was 100 % and it was maintained above 20 % manually by controlling the agitation. After every 24 h of growth, the optical density (O.D.) of the samples at 600 nm was measured and viable cell count and spore count were calculated. The plate count method was used to determine the number of viable cells during B. subtilis strain B1 growth in the bioreactor [35]. For spore count, the culture was incubated at 80 °C for 10 min in a water bath. It was then serially diluted and plated on nutrient agar and the observation was made after 24 h.
Results
Structural Characterization of the Sapstain Fungus During Antagonism
The antagonistic ability of B. subtilis B1 against L. theobromae is evident from the observed structural changes in the fungal mycelia during the dual culture (Fig. 1a, b). The fungal mycelia from the zone of inhibition of the dual culture showed swelling and distortions, while the control mycelia were thin, clear and slender under light microscope (Fig. 1c, d). In the scanning electron microscope, the distortion of the fungal mycelia from the inhibition zone was visible and plasmolysis as well as shrinkage of the fungal hyphae leading to the death of the fungus was also observed (Fig. 1e, f).
Pure and dual culture of Lasiodiplodia theobromae under light microscope and SEM. a Pure culture of Lasiodiplodia theobromae isolated from infected rubberwood pieces. b Dual culture showing the effective inhibition of L. theobromae by B. subtilis. c Thin slender hyphae of normal L. theobromae under light microscope. d Distorted fungal hyphae from the zone of inhibition under light microscope. e Clear normal mycelia under scanning electron microscope. f Plasmolysed and shrunken fungal mycelia from the zone of inhibition under scanning electron microscope
MALDI-TOF-MS Analysis of Antifungal Lipopeptides
The lipopeptide profiling of B. subtilis B1 responsible for the inhibition of sapstain fungus was performed by MALDI-TOF-MS. The whole-cell surface extract MALDI spectrum of B. subtilis B1 grown in PDA control plate and the B. subtilis B1 obtained from the dual culture clearly distinguished the lipopeptide profiles responsible for antagonism (Fig. S1a, b). The mass spectra obtained from the whole-cell surface extract of B. subtilis B1 from the dual culture showed clear peak clusters of the members of iturin, surfactin and fengycin families (Figs. 2a, b), while these peak clusters were almost absent in the spectrum from the control plate. The peaks at m/z 994.44, 1008.45, 1022.47 and 1036.49 (Fig. 2a) observed in the mass spectra were the protonated forms of C12 to C15 surfactin homologues [30]. The peaks at m/z 1030.43, 1044.45, 1058.47 and 1072.47 (Fig. 2a) in the mass spectra were the protonated forms of C13 to C16 iturin C homologues, while the peaks at m/z 1017.4, 1031.4, 1045.4 and 1059.4 (Fig. 2a) were the protonated forms of C13 to C16 homologues of bacillomycin D, respectively [38, 44]. In addition to these four antifungal lipopeptides, two other antifungal lipopeptides which are not commonly mentioned, mycobacillin (protonated forms of C14 to C16 homologues) and trimethyl silyl derivative of protonated, sodium and potassium adducts of bacilysin were also detected in the MALDI-TOF-MS analysis based on their molecular weight and observed peaks (Figs. 2b, c; Table S2).
MALDI-TOF mass spectra of Bacillus subtilis B1 cell surface extracts during the inhibition of sapstain fungus. a Peaks of protonated as well as sodium and potassium adducts of bacillomycin D (m/z 1017–1059), iturin C (m/z 1030–1096) and surfactin (m/z 994–1046). b Peaks of protonated as well as sodium and potassium adducts of fengycin A and B (m/z 1433–1515) and mycobacillin (m/z 1529–1557). c Peaks of protonated as well as sodium and potassium adducts of trimethyl silyl derivative of bacilysin (m/z 415–453)
Characterization of Antifungal Lipopeptide Biosynthetic Genes Using RT-PCR
RT-PCR carried out to confirm the gene expressions of antifungal lipopeptides (viz. bacilysin, fengycin, bacillomycin, mycosubtilin, surfactin and iturin) during antagonism gave rise to specific amplified products of 500, 964, 875, 550, 675 and 650 bp for these lipopeptide genes, respectively (Fig. S2). NCBI-BLAST homology searches were carried out to confirm the coding sequences of these respective lipopeptide genes.
Scale-Up Production of Bacillus subtilis B1 in Bioreactor
The batch cultivation of B. subtilis B1 in the 3 L bioreactor with controlled optimal conditions of 1 lpm aeration, 250 rpm agitation and 20 % dissolved oxygen could scale up the production in 24 h and the viable cell count was 1.13 × 1011 CFU ml−1 after 24 h (Table S3). The optical density value at 600 nm and viable cell and spore counts after each 24 h up to 168th hour (7th day) are given in Table S4.
Discussion
The biocontrol potential of B. subtilis has been mainly attributed to the ability to produce non-ribosomal antifungal lipopeptides with synergistic effects [3, 45]. The inhibition of the fungal growth by an antagonistic bacterium is generally accomplished through plasmolysis, shrinkage and lysis of the fungal mycelium [45]. Lytic antifungal lipopeptides alter the structure of cell membrane and lead to increased permeability with leakage of metabolites and fungal cell death [7]. The plasmolysis, shrinkage and lysis of the fungal hyphae observed in the present study have been reported previously against Curvularia lunata, Colletotrichum gloeosporioides and Lasiodiplodia theobromae [3, 5, 15]. RT-PCR analysis performed from the B. subtilis B1 colonies at the time of dual culture confirmed the expression of lipopeptide biosynthetic genes, coding for surfactin, fengycin, iturin, bacillomycin, mycosubtilin and bacilysin.
Antifungal lipopeptides from the whole-cell surface extracts of B. subtilis have been reported previously using MALDI-TOF-MS [4, 46]. This is the first instance of employing MALDI-TOF-MS for the precise identification of the antifungal lipopeptides by B. subtilis B1 against rubberwood sapstain fungus (L. theobromae). Generally, bacterial antibiotics are best produced in the antibiotic production medium, Landy agar. But in the presence of the fungus, the bacteria are capable of producing the essential antifungal lipopeptides even in the growth medium (PDA) to antagonize the fungus. High antibiotic production was also reported in the inhibition zone of dual culture in PDA medium [24]. In the present study, the MALDI-TOF-MS spectrum (Figs S1a, b) of the cell surface extract, for control as well as dual cultured B. subtilis B1 with sapstain fungus on PDA medium, clearly substantiated the presence of antifungal lipopeptides on bacterial cell surface extract.
The inhibitory effects of the iturin family lipopeptides are reported to be based on the osmotic perturbation due to the formation of ion-conducting pores on cell membrane [25]. The permeability of yeast plasma membrane is reported to be altered by mycosubtilin and bacillomycin with tyrosine residue, which resulted in the release of nucleotides, proteins and lipids [23, 39, 49]. Iturin A is the commonly produced antifungal antibiotic of the iturin family produced by B. subtilis [21]. But in the present study, instead of iturin A (m/z 1043.5, 1057.5, 1071.5) another antibiotic iturin C (m/z 1044.45, 1058.48, 1072.48), with the m/z value varying by 1 Da due to asparagine (Asn) to aspartic acid (Asp) replacement at amino acid position 1, was identified [33]. This is the first report on the identification of iturin C from B. subtilis whole cell during sapstain fungal inhibition using MALDI-TOF-MS analysis. Similarly, LC–ESI–MS analysis of the lipopeptides of banyan endophyte B. subtilis could reveal the presence of iturin C [34]. Another member of iturin family, bacillomycin D, is also identified during the sapstain fungal inhibition. C13 isoform of bacillomycin D has been detected in the present study, whereas only C14–C17 isoforms were previously reported [38]. The long-chain iturins are more hydrophobic, readily form oligomers and therefore may interact more effectively with ergosterol-containing membranes of fungi and yeast [27]. In this study, C16 homologue of iturin C and C17 homologue of bacillomycin have been detected by the MALDI assay which can also contribute strongly for the fungal inhibition. Even though RT-PCR could detect the expressions of mycosubtilin gene and itu D gene (coding for iturin A) during inhibition, its presence in the form of m/z peaks was not detected in MALDI-TOF-MS.
Iturin with its amphiphilic nature can readily associate and tightly anchor into lipid layers and can form irreversible pores by the insertion of surfactin-rich clusters in the membrane and causes synergistic effect through membrane solubilization or disruption [21, 26, 27, 31, 37]. Surfactin-producing B. subtilis strains have high swarming motility and biofilm formation potential which in turn results in the bacterial cell motion [22]. This is evidenced by the even distribution of B. subtilis cells on the wood blocks after 1 week of inoculation. The lipopeptides, iturin and surfactin are surface-active substances which promote adhesion of B. subtilis onto diverse solid substrates by changing the hydrophobicity of the cells [2].
Among the three antifungal lipopeptide families, fengycins are reported as the most effective with high fungicidal, bactericidal and insecticidal properties [16, 20]. Even in low concentrations, fengycin acts as detergents which solubilize the membranes by interacting with the lipid layers and forms pores on them [10]. The production of all the five reported homologues of fengycin A and fengycin B during the fungal inhibition was clearly observed in the present MALDI-TOF-MS analysis [46]. The synergistic action of surfactin and iturin, surfactin and fengycin as well as iturin and fengycin had been reported previously for the biological control of fungal pathogens [26, 32, 40].
The cyclic tri-decapeptide mycobacillin, which is antifungal in nature, lacks the hydrocarbon tail but it binds to fungal cell membrane by its tyrosine residue and solubilizes it [30]. MALDI spectrum of mycobacillin has not been reported previously. Based on the reported molecular weight of mycobacillin (1528 Da), three homologues of mycobacillin (1529.6, 1543.6 and 1557.6) could be identified in the present study [50]. The presence of protonated as well as the sodium and potassium adducts of trimethyl silyl derivative of bacilysin in this study clearly indicates the role of bacilysin also in the sapstain fungal inhibition [50]. Chung et al. [9] had confirmed the trimethyl silyl derivative of bacilysin peak (m/z 415) in the GC–MS analysis of the B. subtilis culture filtrate.
Earlier studies reported molasses as one of the ingredients in the bacterial growth medium along with other nitrogen sources [52]. The viable cells obtained in the present batch cultivation after 24 h was high as compared to the mass production of B. subtilis in batch reaction with low-cost medium containing soyflour and molasses [51].
The present study could identify specific antifungal lipopeptides viz. iturin C, surfactin, fengycin A and B, bacillomycin D, bacilysin and mycobacillin produced by B. subtilis B1 during the inhibition of sapstain fungus, L. theobromae, using MALDI-TOF-MS as well as could confirm the expression of the lipopeptide biosynthetic genes in B. subtilis B1 through RT-PCR. More studies using real-time PCR are warranted to further quantify the expression levels of antibiotic genes during the sapstain fungal antagonism. Mass production of the biocontrol agent, B. subtilis B1, against the sapstain fungus on rubberwood using an economically viable medium offers scope for its commercialization. Further experiments are progressing in our lab for the formulation and field efficacy testing of the biocontrol agent as well as for the real-time quantification of lipopeptide biosynthetic gene expression levels during antagonism.
References
Adeniyi DO, Adedeji AR, Oduwaye OF, Kolawole OO (2013) Evaluation of biocontrol agents against Lasiodiplodia theobromae causing inflorescence blight of cashew in Nigeria. IOSR-JAVS 5:46–48
Ahimou F, Jacques P, Deleu M (2000) Surfactin and iturin effects on Bacillus subtilis surface hydrophobicity. Enzyme Microbe Technol 27:749–754
Ashwini N, Srividya S (2014) Potentiality of Bacillus subtilis as biocontrol agent for management of anthracnose disease of chilli caused by Colletotrichum gloeosporioides. Biotech 4:127–136
Athukorala SNP, Fernando WGD, Rashid KY (2009) Identification of antifungal antibiotics of Bacillus species isolated from different microhabitats using polymerase chain reaction and MALDI-TOF mass spectrometry. Can J Microbiol 55:1021–1032
Basha S, Ulaganathan K (2002) Antagonism of Bacillus species (strain BC121) towards Curvularia lunata. Curr Sci 82:1457–1463
Benko R (1988) Bacteria as possible organisms for biological control of blue stain. The International Research Group on Wood Preservation Document No: IRG/WP/1339, Stockholm, Sweden
Brogden KA (2005) Antimicrobial peptides: pore formers or metabolic inhibitors in bacteria. Nat Rev Microbiol 3:238–250
Bruce A, Stewar D, Verrall S, Wheatly RE (2003) Effect of volatiles from bacteria and yeast on the growth and pigmentation of sapstain fungi. Int Biodeter Biodegr 51:101–108
Chung S, Kong H, Buyer JS, Lakshman DK, Lydon J, Kim S, Roberts DP (2008) Isolation and partial characterization of Bacillus subtilis ME488 for suppression of soil borne pathogens of cucumber and pepper. Appl Microbiol Biotechnol 80:115–123
Deleu M, Paquot M, Nylander T (2005) Fengycin interaction with lipid monolayers at the air-aqueous interface-implications for the effect of fengycin on biological membranes. J Colloid Interface Sci 283:358–365
Fravel DR (2005) Commercialization and implementation of biocontrol. Annu Rev Phytopathol 43:337–359
George J (1985) Preservative treatment of bamboo, rubberwood and coconut palm—simple methods for treating building timbers. In: Findlay WPK (ed) Preservation of timber in the tropics. Kluwer, Massachusetts, pp 233–248
George JG, Chandrashekar HM (2014) Growth and trends in production and marketing of natural rubber in Kerala, India. Int J Curr Res Aca Rev 2:53–61
Haggag WM, Nofal MA (2006) Improving the biological control of Botryodiplodia disease on some Annona cultivars using single or multi-bioagents in Egypt. Biol Control 38:341–349
Hashem M, Alamri S (2009) The biocontrol of post harvest disease (Botryodiplodia theobromae) of guava (Psidium guajava L.) by the application of yeast strains. Postharvest Biol Tech 53:123–130
Hofemeister J, Conrad B, Adler B, Hofemeister B, Feesche J, Kucheryava N, Steinborn G, Franke P, Grammel N, Zwintscher A, Leenders F, Hitzeroth G, Vater J (2004) Genetic analysis of the biosynthesis of non-ribosomal peptide and polyketide like antibiotics, iron uptake and biofilm formation by Bacillus subtilis A1/3. Mol Genet Genomics 272:363–378
Hsieh FC, Li MC, Lin TC, Kao SS (2004) Rapid detection and characterization of surfactin producing Bacillus subtilis and closely related species based on PCR. Curr Microbiol 49:186–191
Jacques P, Hbid C, Destain J, Razafindralambo H, Paquot M, De Pauw E, Thonart P (1999) Optimization of biosurfactant lipopeptide production from Bacillus subtilis S499 by Plackett-Burman design. Appl Biochem Biotechnol 77:223–233
Johnson LF, Curl EA (1972) Methods for research on the ecology of soil-borne plant pathogens. Burgess Publishing Company, Minneapolis
Kim PI, Bai H, Bai D, Chae H, Chung S, Kim Y, Park R, Chi YT (2004) Purification and characterization of a lipopeptide produced by Bacillus thuringiensis CMB26. J Appl Microbiol 97:942–949
Kim PI, Ryu J, Kim YH, Chi Y (2010) Production of biosurfactant lipopeptides iturin A, fengycin and surfactin A from Bacillis subtilis CMB32 for control of Colletotrichum gloeosporiodes. J Microbiol Biotechnol 20:138–145
Kinsinger RF, Shirk MC, Fall R (2003) Rapid surface motility in Bacillus subtilis is dependent on extracellular surfactin and potassium ion. J Bacteriol 185:5627–5631
Leclere V, Bechet M, Adam A, Guez J, Wathelet B, Ongena M, Thonart P, Gancel F, Chollet-Imbert M, Jacques P (2005) Mycosubtilin overproduction by Bacillus subtilis BBG100 enhances the organism’s antagonistic and biocontrol activities. App Environ Microbiol 71:4577–4584
Leenders F, Stein TH, Kablitz B, Franke P, Vater J (1999) Rapid typing of Bacillus subtilis strains by their secondary metabolites using matrix assisted laser desorption/ionization mass spectrometry of intact cells. Rapid Commun Mass spectrum 13:943–949
Maget-Dana R, Peypoux F (1994) Iturins, a special class lipopeptides: biological and physicochemical properties. Toxicology 87:157–174
Maget-Dana R, Thimon L, Peypoux F, Ptack M (1992) Surfactin/Iturin A interaction may explain the synergistic effect of surfactin on the biological properties of iturin A. Biochimie 74:1047–1051
Malfanova NV (2012) Cyclic lipopeptide profile of the plant beneficial endophytic bacterium Bacillus subtilis HC8. Arch Microbiol 194:893–899
Mora I, Cabrefiga J, Montesinos E (2011) Antimicrobial peptide genes in Bacillus strains from plant environment. Inter Microbiol 14:213–223
Moszer I, Jones L, Moreira S, Fabry C, Danchin A (2002) Subti List: the reference database for the Bacillus subtilis genome. Nucleic Acids Res 30:62–65
Mukherjee S, Bose SK (1978) Some observations on the nature of reactive groups involved in reversal of mycobacillin inhibition by sterols and lipids. J Antibiot 31:147–149
Ongena M, Jacques P (2008) Bacillus lipopeptides: versatile weapons for plant disease biocontrol. Trends Microbiol 16:115–125
Ongena M, Jourdan E, Adam A, Paquot M, Brans A, Joris B, Arpiqny JL, Thonart P (2007) Surfactin and fengycin lipopeptides of Bacillus subtilis as elicitors of induced systemic resistance in plants. Environ Microbiol 9:1084–1090
Park JK, Hasumi K, Endo A (1995) Inhibition of the binding of oxidized low density lipoprotein to the macrophages by iturin C related compounds. J Antibiot (Tokyo) 48:226–232
Pathak KV, Keharia H (2014) Identification of surfactins and iturins produced by potent fungal antagonist, Bacillus subtilis K1 isolated from aerial roots of banyan (Ficus benghalensis) tree using mass spectrometry. 3. Biotechnology 4:283–295
Postgate JR (1969) Methods in microbiology. Academic Press, London
Prashar P, Kapoor N, Sachdeva S (2013) Biocontrol of plant pathogens using plant growth promoting bacteria. Sustain Agr Rev 12:319–360
Rahman MS, Ano T, Shoda M (2006) Second stage production of iturin A by induced germination of Bacillus subtilis RB14. J Biotech 125:513–515
Ramarathnam R (2007) Phyllosphere bacterial biological control of Leptosphaeria maculans, the blackleg pathogen of canola (Brassica napus L.): screening for potential antibiotic producers, investigation of the mechanism of control, biochemical detection of the antifungal compounds and establishment of the role of antibiosis. Ph.D. Thesis, University of Manitoba, Winnipeg, Manitoba
Ramarathnam R, Bo S, Chen Y, Fernando WGD, Xuewen G, de Kievit T (2007) Bacillomycin D producing Bacillus spp., antagonistic to fungal pathogens of canola and wheat. Can J Microbiol 53:901–911
Romero D, de Vicente A, Rakotoaly RH, Dufour SE, Veening JW, Arrebola E, Cazorla FM, Kuipers OP, Paquot M, Perez-Garcia A (2007) The iturin and fengycin families of lipopeptides are key factors in antagonism of Bacillus subtilis toward Podosphaera fusca. Mol Plant Microbe Interact 20:430–440
Sajitha KL, Florence EJM (2013) Effects of Streptomyces sp. on growth of rubberwood sapstain fungus Lasiodiplodia theobromae. J Trop For Sci 25:393–399
Sajitha KL, Florence EJM, Dev SA (2014) Screening of bacterial biocontrol against sapstain fungus (Lasiodiplodia theobromae Pat.) of rubberwood (Hevea brasiliensis Muell. Arg.). Res Microbiol 165:541–548
Sangeetha G, Usharani S, Muthukumar A (2009) Biocontrol with Trichoderma species for the management of postharvest crown rot of banana. Phytopathol Mediterr 48:214–222
Steller S, Vater J (2000) Purification of the fengycin synthetase multienzyme system from Bacillus subtilis b213. J Chromato Biomed Sci 737:267–275
Susi P, Aktuganov G, Himanen J, Korpela T (2011) Biological control of wood decay against fungal infection. J Environ Manage 92:1681–1689
Vater J, Barbel K, Wilde C, Frnake P (2002) Matrix assisted laser desorption ionization time of flight mass spectrometry of lipopeptide biosurfactants in whole cells and culture filtrates of Bacillus subtilis C-1 isolated from petroleum sludge. Appl Environ Microbiol 68:6210–6219
Vater J, Gao X, Hitzeroth G, Wilde C, Franke P (2003) “Whole cell”—matrix assisted laser desorption ionization—time of flight mass spectrometry, an emerging technique for efficient screening of biocombinatorial libraries of natural compounds- present state of research. Comb Chem High Throughput Screen 6:557–567
Veenin T, Veenin A, Denrungruang P (1999) Biological control of stain fungus in rubberwood (Hevea brasiliensis Muell. Arg) by Trichoderma sp. Thai J For 18:73–86
Volpon L, Besson F, Lancelin JM (1999) NMR structure of active and inactive forms of the sterol-dependent antifungal antibiotic bacillomycin L. Eur J Biochem 264:200–210
Walker JE, Abraham EP (1970) The structure of bacilysin and other products of Bacillus subtilis. Biochem J 118:563–570
Yanez-Mendizabal V, Vinas I, Usall J, Torres R, Solsona C, Teixido N (2012) Production of the postharvest biocontrol agent Bacillus subtilis CPA-8 using low cost commercial products and by-products. Biol Contr 60:280–289
Younis MA, Hezayen M, Nour-Eldein FF, Shabeb MSA (2010) Optimization of cultivation medium and growth conditions for Bacillus subtilis KO strain isolated from sugar cane molasses. Am Eurasian J Agric Environ Sci 7:31–37
Acknowledgments
This study was conducted at Kerala Forest Research Institute, Peechi, Thrissur, India, supported by Grants (BT/PR14542/AGR/05/527/2010) from the Department of Biotechnology, Ministry of Science and Technology, Government of India.
Author information
Authors and Affiliations
Corresponding author
Ethics declarations
Conflict of Interest
The authors declare that they have no conflict of interests.
Electronic Supplementary Material
Below is the link to the electronic supplementary material.
Rights and permissions
About this article
Cite this article
Sajitha, K.L., Dev, S.A. & Maria Florence, E.J. Identification and Characterization of Lipopeptides from Bacillus subtilis B1 Against Sapstain Fungus of Rubberwood Through MALDI-TOF-MS and RT-PCR. Curr Microbiol 73, 46–53 (2016). https://doi.org/10.1007/s00284-016-1025-9
Received:
Accepted:
Published:
Issue Date:
DOI: https://doi.org/10.1007/s00284-016-1025-9